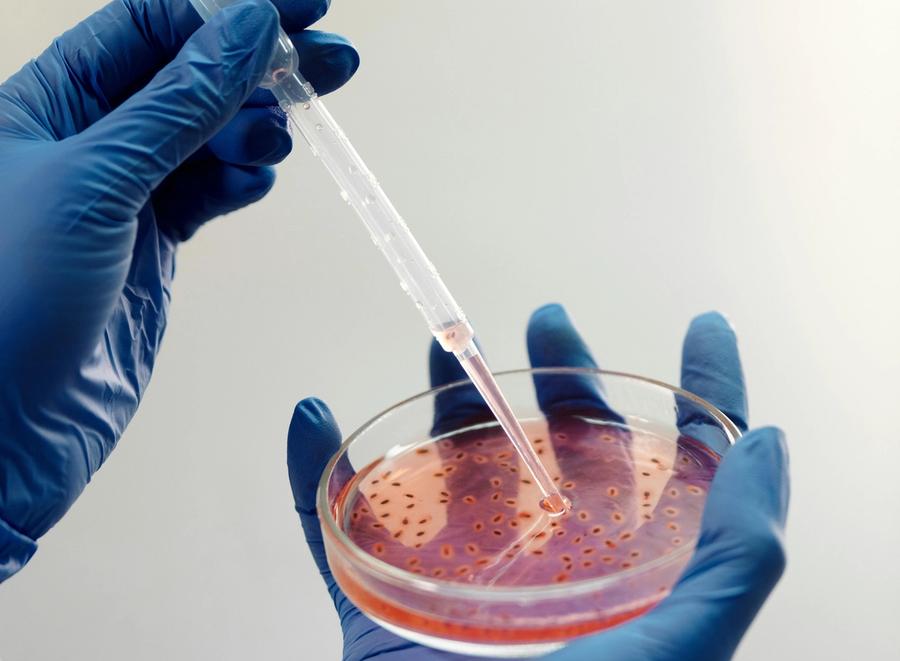

Chodzi o przypadek pacjenta, który trafił w złym stanie do Queen Elizabeth The Queen Mother Hospital w Margate wieczorem 11 marca. Mimo że personel już następnego dnia podejrzewał meningitis, zgłoszenie do brytyjskiej agencji bezpieczeństwa zdrowotnego (UKHSA) nastąpiło dopiero 13 marca, po potwierdzeniu diagnozy.
Zgodnie z obowiązującymi przepisami, takie przypadki powinny być raportowane natychmiast – bez czekania na wyniki badań laboratoryjnych.
Minister zdrowia Wes Streeting skomentował sprawę jednoznacznie, mówiąc, że opóźnienie „nie jest akceptowalne i nie jest wystarczająco dobre”. Jednocześnie zaznaczył, że na ten moment nie ma dowodów, aby zwłoka miała istotny wpływ na rozwój ogniska choroby.
Zarządzający placówką East Kent Hospitals University Foundation Trust przyznali, że mogli powiadomić UKHSA wcześniej. Jak podkreślił tymczasowy dyrektor wykonawczy dr Des Holden, kontakt z agencją utrzymywany jest od momentu potwierdzenia diagnozy, a działania w zakresie zarządzania przypadkami są prowadzone na bieżąco.
Minister wyjaśnił, że od momentu pojawienia się podejrzenia personel miał obowiązek zgłoszenia sprawy w ciągu 24 godzin. W praktyce zajęło to około 26 godzin.
Mimo krytyki, Streeting podkreślił, że reakcja służb na rozwój sytuacji była szybka i szeroko zakrojona. Wskazał na sprawne działania NHS, współpracę z placówkami edukacyjnymi oraz szybkie uruchomienie programu szczepień.
Jednocześnie zaznaczył, że sytuacja wciąż nie jest w pełni opanowana. W najbliższych tygodniach mogą pojawiać się kolejne przypadki, co jest typowe dla tego typu zakażeń, dlatego konieczne jest dalsze monitorowanie i testowanie.
Do tej pory w wyniku ogniska choroby zmarły dwie osoby – 18-letnia Juliette Kenny oraz student Uniwersytetu w Kent. Większość zakażonych to osoby młode, a mediana wieku wynosi 19 lat. Choć większość przypadków dotyczy studentów, część chorych nie jest związana z uczelniami.
Z danych UKHSA wynika, że aż 87% zakażonych przebywało wcześniej w klubie nocnym Club Chemistry w Canterbury między 5 a 7 marca.
Według najnowszych informacji potwierdzono 20 przypadków zapalenia opon mózgowych, a kolejne dwa są w trakcie analizy. To spadek względem wcześniejszych danych z weekendu, kiedy liczba zgłoszeń była wyższa.
Program szczepień dla studentów Uniwersytetu w Kent rozpoczął się 18 marca i nadal jest kontynuowany.